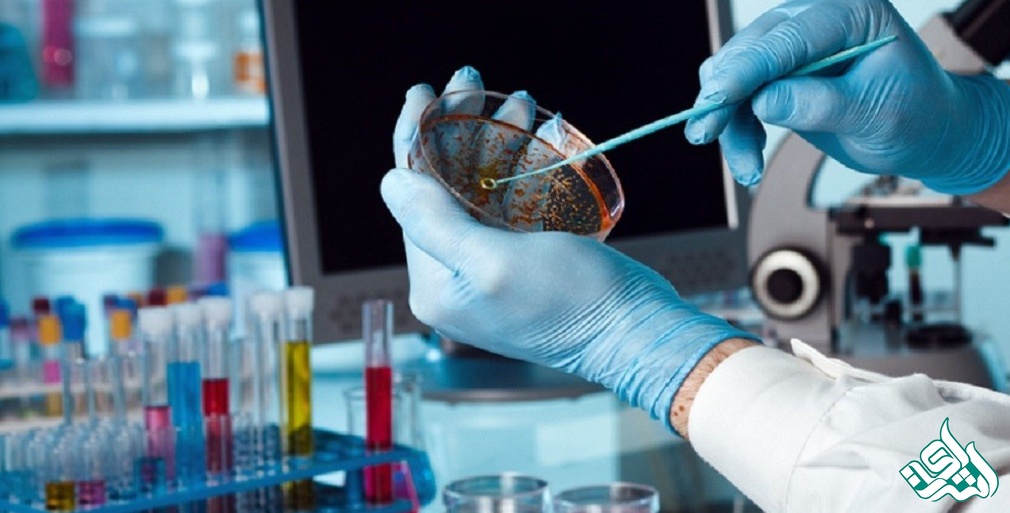

موسسه انتشاراتی اشراق: لیست مجلات ISI ایمپکت دار میکروبیولوژی پزشکی برای استفاده علاقمندان به چاپ مقاله در این مجلات قرار داده شده است.
نشریاتی که در فهرست ISI قرار دارند موضوعات تخصصی بسیار زیادی را در بر میگیرند. موضوعاتی همچون علوم کشاورزی، زیستشناسی و بیوشیمی، علوم کامپیوتر، اکولوژی و محیط زیست، اقتصاد، تجارت، مهندسی، علوم زمین، ایمونولوژی تا ریاضیات و علوم فضایی و فیزیک و فارماکولوژی و… . هریک از افراد بسته به تخصص زمینه فعالیت خود در هریک از حوزههای تحقیقاتی، میتوانند مقالات خود را برای نشریات مرتبط به رشته تخصص خود ارسال کنند و در انتظار داوری مقاله خود باشند. از جمله دلایلی که برای پذیرش یک مجله در فهرست این موسسه وجود دارد عبارت است از:
هماهنگی ویژگیهای مجله با معیارهای کمیته علمی موسسه
تنوع بینالمللی مقالات چاپشده در هر مجله
نشر بهموقع و منظم مجله
همانطور که عنوان شد ملاک ISI بودن یا نبودن یک مجله، قرار گرفتن نام آن مجله در فهرست مجلات موسسه تامسون رویترز میباشد. بنابراین برای بررسی اینکه مجلهای ISI میباشد یا خیر، میبایست به وبسایت این موسسه به نشانی http://mjl.clarivate.com/ مراجعه نموده و نام مجله و یا شاپای مجله (ISSN) را جستجو کنید. در صورتیکه نام مجله در نتایج جستجو نمایش داده شود، مجله مورد نظر شما جزو مجلات ISI میباشد. بیش از 1500 مجله در هر سال به فهرست این موسسه اضافه میشود، اما این را هم باید بدانید که اگر مجلهای به پانتئون مجلات پایگاه ISI اضافه میشود، این حضور تا ابد نخواهد بود و امکان دارد که سال بعد نتواند معیارهای حضور را حفظ کند و از فهرست خارج شود. به همین منظور باید به وبسایت تامسون رویترز مراجعه نموده و نام و یا ISSN مجله را جستجو نمایید.
نکته: بهتر است به جای نام مجله، ISSN مجله را جستجو نمایید.

همانطور که در مطالب قبلی بیان شد مجلات یا ژورنال های ISI، مجلاتی هستند که در لیست مجلات موسسه تامسون رویترز قرار دارند و مجلات معتبری هستند. اما پرسشی که مطرح میشود این است که آیا همه مجلات ISI، دارای اعتبار یکسانی هستند و بین آنها تفاوتی نیست؟ مسلماً جواب این پرسش، این است که همه مجلات ISI از نظر اعتبار در سطح یکسانی قرار ندارد و برخی مجلات معتبرتر از مجلات دیگر هستند. اما ملاک رتبهبندی مجلات ISI چیست؟ ملاکی که موسسه تامپسون رویترز برای ارزشدهی به مجلات ISI استفاده میکند، "ایمپکت فاکتور (IF)" و یا "ضریب تاثیر" نام دارد و بهصورت میانگین تعداد دفعاتی که به مقالات یک مجله در دو سال قبل رفرنس داده شده است، تعریف میگردد. در واقع ضریبتاثیر، معیاری است که به واسطه آن، تعداد استنادات یا همان مرجعخوردنهای مقالات یک ژورنال را بهطور میانگین نشان میدهند. هر چقدر که این شاخص بیشتر باشد، ارزش و اعتبار مجله هم بالاتر خواهد رفت. چون بالابودن شاخص ضریبتاثیر برای هر ژورنال نشان میدهد که تعداد "سایتیشنها (citation)" یا همان استناد مقالات دیگر به مقالات موجود در مجله زیاد بوده است. مجلات "JCR" بهطور سختگیرانهتری اقدام به پذیرش مقالات میکنند.
لیست مجلات ISI ایمپکت دار میکروبیولوژی پزشکی برای استفاده علاقمندان و دانشجویان این رشته برای سابمیت و چاپ مقالات خود قرار داده شده است.
توضیحات مربوط به جدول:
تعداد مقالات منتشر شده در سال (2017 :Total Docs (2017
تعداد مقالات منتشر شده در 3 سال اخیر : (Total ocs. (3years
تعداد کل رفرنس های مقالات چاپ شده در سال 2017 : Total Refs
میانگین رفرنس های بکار رفته در مقالات چاپ شده در سال 2017 : Ref./oc
|
| Type | SJR | H index | Total Docs. (2017) | Total Docs. (3years) | Total Refs. | Total Cites (3years) | Citable Docs. (3years) | Cites / Doc. (2years) | Ref. / Doc. |
1 | Clinical Microbiology Reviews | journal | 11.301 Q1 | 232 | 32 | 110 | 9433 | 2470 | 106 | 21.82 | 294.78 |
2 | Nature Microbiology | journal | 7.139 Q1 | 24 | 209 | 266 | 7984 | 2072 | 213 | 9.73 | 38.20 |
3 | Microbiome | journal | 5.171 Q1 | 36 | 103 | 175 | 3795 | 1645 | 165 | 8.32 | 36.84 |
4 | Clinical Infectious Diseases | journal | 5.051 Q1 | 288 | 821 | 2539 | 20943 | 13686 | 1632 | 8.36 | 25.51 |
5 | Trends in Microbiology | journal | 4.639 Q1 | 164 | 147 | 349 | 7555 | 2766 | 309 | 8.61 | 51.39 |
6 | Current Opinion in Microbiology | journal | 3.814 Q1 | 155 | 134 | 378 | 7694 | 2259 | 341 | 6.71 | 57.42 |
7 | Emerging Infectious Diseases | journal | 3.278 Q1 | 198 | 536 | 1625 | 9434 | 7683 | 1049 | 7.18 | 17.60 |
8 | Clinical Microbiology and Infection | journal | 2.569 Q1 | 122 | 316 | 1139 | 7172 | 5162 | 966 | 4.80 | 22.70 |
9 | Infectious Disease Clinics of North America | journal | 2.359 Q1 | 82 | 61 | 158 | 4323 | 771 | 136 | 5.84 | 70.87 |
10 | Gut Microbes | journal | 2.279 Q1 | 41 | 72 | 218 | 2197 | 975 | 183 | 5.76 | 30.51 |
11 | Journal of Clinical Microbiology | journal | 2.256 Q1 | 226 | 459 | 2145 | 12234 | 7567 | 1895 | 3.95 | 26.65 |
12 | Journal of Infection | journal | 2.185 Q1 | 86 | 213 | 649 | 6265 | 2143 | 454 | 4.70 | 29.41 |
13 | Current Topics in Microbiology and Immunology | book series | 2.138 Q1 | 105 | 136 | 297 | 16611 | 1111 | 216 | 7.13 | 122.14 |
14 | Infection Control and Hospital Epidemiology | journal | 1.970 Q1 | 122 | 321 | 952 | 5861 | 2452 | 700 | 2.86 | 18.26 |
15 | Microbiology spectrum | journal | 1.814 Q1 | 21 | 124 | 526 | 11596 | 1683 | 526 | 3.12 | 93.52 |
16 | Current Opinion in Infectious Diseases | journal | 1.813 Q1 | 90 | 78 | 256 | 4931 | 925 | 243 | 3.91 | 63.22 |
17 | International Journal of Medical Microbiology | journal | 1.717 Q1 | 79 | 100 | 295 | 3072 | 1053 | 284 | 3.21 | 30.72 |
18 | Frontiers in cellular and infection microbiology | journal | 1.703 Q1 | 43 | 530 | 500 | 35361 | 1973 | 463 | 3.51 | 66.72 |
19 | Frontiers in Microbiology | journal | 1.699 Q1 | 69 | 2642 | 4432 | 167561 | 18443 | 4225 | 4.08 | 63.42 |
20 | International Journal of Antimicrobial Agents | journal | 1.699 Q1 | 107 | 273 | 759 | 8517 | 2673 | 581 | 4.42 | 31.20 |
21 | Journal of Hospital Infection | journal | 1.660 Q1 | 103 | 306 | 648 | 4932 | 1618 | 440 | 3.46 | 16.12 |
22 | Virulence | journal | 1.635 Q1 | 43 | 208 | 366 | 8226 | 1101 | 232 | 3.85 | 39.55 |
23 | Antimicrobial Resistance and Infection Control | journal | 1.573 Q1 | 20 | 126 | 148 | 4296 | 512 | 143 | 3.60 | 34.10 |
24 | Journal of Oral Microbiology | journal | 1.541 Q1 | 24 | 10 | 69 | 512 | 303 | 63 | 4.90 | 51.20 |
25 | International Journal of Infectious Diseases | journal | 1.514 Q1 | 70 | 317 | 937 | 9461 | 2607 | 839 | 3.24 | 29.85 |
26 | Pathogens | journal | 1.421 Q1 | 18 | 68 | 171 | 5453 | 600 | 165 | 3.48 | 80.19 |
27 | Pediatric Infectious Disease Journal | journal | 1.392 Q1 | 131 | 337 | 1265 | 6929 | 2532 | 1051 | 2.27 | 20.56 |
28 | Clinical and Vaccine Immunology | journal | 1.320 Q1 | 95 | 103 | 499 | 5044 | 1295 | 481 | 2.79 | 48.97 |
29 | European Journal of Clinical Microbiology and Infectious Diseases | journal | 1.312 Q1 | 93 | 329 | 831 | 10021 | 2327 | 812 | 2.67 | 30.46 |
30 | Medical Microbiology and Immunology | journal | 1.287 Q1 | 52 | 46 | 168 | 2111 | 455 | 160 | 3.15 | 45.89 |
31 | Infection, Genetics and Evolution | journal | 1.278 Q1 | 69 | 351 | 1224 | 15588 | 3255 | 1182 | 2.59 | 44.41 |
32 | Future Microbiology | journal | 1.270 Q2 | 64 | 147 | 435 | 6789 | 1268 | 407 | 2.86 | 46.18 |
33 | Expert Review of Anti-Infective Therapy | journal | 1.264 Q2 | 62 | 105 | 387 | 9233 | 1138 | 365 | 2.89 | 87.93 |
34 | Tuberculosis | journal | 1.264 Q2 | 77 | 92 | 410 | 3860 | 1052 | 392 | 2.60 | 41.96 |
35 | Infectious Diseases and Therapy | journal | 1.256 Q2 | 12 | 40 | 113 | 2009 | 325 | 106 | 3.19 | 50.23 |
36 | Pathogens and Disease | journal | 1.244 Q2 | 91 | 115 | 391 | 5656 | 975 | 373 | 2.38 | 49.18 |
37 | BMC Microbiology | journal | 1.242 Q2 | 88 | 230 | 917 | 10581 | 2695 | 901 | 2.85 | 46.00 |
38 | Food Packaging and Shelf Life | journal | 1.239 Q2 | 14 | 63 | 105 | 2500 | 402 | 104 | 3.61 | 39.68 |
39 | Molecular Oral Microbiology | journal | 1.210 Q2 | 67 | 41 | 110 | 2142 | 337 | 106 | 2.41 | 52.24 |
40 | Memorias do Instituto Oswaldo Cruz | journal | 1.172 Q2 | 76 | 124 | 438 | 3682 | 1082 | 425 | 2.81 | 29.69 |
41 | Infection | journal | 1.171 Q2 | 64 | 139 | 416 | 3670 | 929 | 364 | 2.71 | 26.40 |
42 | Sexually Transmitted Diseases | journal | 1.160 Q2 | 95 | 151 | 470 | 3562 | 791 | 397 | 1.81 | 23.59 |
43 | Diagnostic Microbiology and Infectious Disease | journal | 1.157 Q2 | 86 | 230 | 776 | 5856 | 1851 | 759 | 2.39 | 25.46 |
44 | Annals of Clinical Microbiology and Antimicrobials | journal | 1.104 Q2 | 42 | 77 | 171 | 2486 | 500 | 169 | 3.17 | 32.29 |
45 | Antibiotics | journal | 1.063 Q2 | 16 | 39 | 116 | 2276 | 330 | 112 | 2.73 | 58.36 |
46 | Beneficial microbes | journal | 0.962 Q2 | 26 | 77 | 225 | 3633 | 588 | 217 | 2.22 | 47.18 |
47 | Microbial Drug Resistance | journal | 0.957 Q2 | 60 | 138 | 278 | 5253 | 645 | 275 | 2.22 | 38.07 |
48 | Journal of Medical Microbiology | journal | 0.914 Q2 | 99 | 247 | 649 | 8736 | 1360 | 577 | 2.13 | 35.37 |
49 | APMIS : acta pathologica, microbiologica, et immunologica Scandinavica | journal | 0.868 Q2 | 80 | 140 | 457 | 5361 | 888 | 428 | 2.13 | 38.29 |
50 | Infectious Diseases | journal | 0.863 Q2 | 66 | 155 | 475 | 3323 | 746 | 411 | 1.92 | 21.44 |
51 | Journal of Infection and Chemotherapy | journal | 0.848 Q2 | 52 | 168 | 507 | 4022 | 901 | 500 | 1.70 | 23.94 |
52 | Brazilian Journal of Infectious Diseases | journal | 0.817 Q2 | 37 | 124 | 401 | 2919 | 616 | 315 | 2.02 | 23.54 |
53 | Journal of Microbiology, Immunology and Infection | journal | 0.789 Q2 | 45 | 247 | 380 | 3626 | 613 | 332 | 1.80 | 14.68 |
54 | Current Issues in Molecular Biology | journal | 0.787 Q2 | 47 | 16 | 36 | 1397 | 89 | 35 | 2.00 | 87.31 |
55 | Methods in Microbiology | book series | 0.744 Q2 | 27 | 4 | 37 | 509 | 46 | 14 | 0.00 | 127.25 |
56 | Surgical Infections | journal | 0.711 Q2 | 50 | 133 | 415 | 4072 | 620 | 382 | 1.69 | 30.62 |
57 | Journal of Microbiological Methods | journal | 0.696 Q2 | 115 | 222 | 784 | 6987 | 1516 | 752 | 1.82 | 31.47 |
58 | International Journal of Microbiology | journal | 0.662 Q2 | 27 | 46 | 112 | 1738 | 252 | 109 | 2.30 | 37.78 |
59 | Journal of Global Antimicrobial Resistance | journal | 0.658 Q2 | 13 | 189 | 257 | 4210 | 385 | 193 | 2.04 | 22.28 |
60 | Revista da Sociedade Brasileira de Medicina Tropical | journal | 0.658 Q2 | 45 | 171 | 483 | 3867 | 618 | 434 | 1.43 | 22.61 |
61 | New Microbiologica | journal | 0.630 Q2 | 33 | 55 | 188 | 1796 | 285 | 181 | 1.41 | 32.65 |
62 | Interdisciplinary Perspectives on Infectious Diseases | journal | 0.627 Q2 | 20 | 8 | 60 | 422 | 116 | 59 | 1.12 | 52.75 |
63 | Japanese Journal of Infectious Diseases | journal | 0.595 Q3 | 47 | 150 | 334 | 3325 | 396 | 285 | 1.14 | 22.17 |
64 | Canadian Journal of Infectious Diseases and Medical Microbiology | journal | 0.548 Q3 | 29 | 37 | 220 | 1306 | 248 | 200 | 1.11 | 35.30 |
65 | Jundishapur Journal of Microbiology | journal | 0.543 Q3 | 17 | 108 | 560 | 3409 | 853 | 543 | 1.48 | 31.56 |
66 | International Journal of Mycobacteriology | journal | 0.535 Q3 | 9 | 82 | 359 | 1950 | 370 | 330 | 1.07 | 23.78 |
67 | Clinical Medicine Insights: Pathology | journal | 0.518 Q3 | 7 | 12 | 18 | 513 | 38 | 18 | 2.91 | 42.75 |
68 | Indian Journal of Medical Microbiology | journal | 0.503 Q3 | 40 | 123 | 509 | 3077 | 388 | 333 | 1.21 | 25.02 |
69 | Journal of Water and Health | journal | 0.493 Q3 | 50 | 94 | 287 | 3594 | 394 | 286 | 1.29 | 38.23 |
70 | Journal of Clinical Tuberculosis and Other Mycobacterial Diseases | journal | 0.467 Q3 | 3 | 26 | 22 | 706 | 22 | 15 | 1.47 | 27.15 |
71 | Journal of Clinical Laboratory Analysis | journal | 0.448 Q3 | 42 | 170 | 359 | 3669 | 429 | 357 | 1.17 | 21.58 |
72 | International Microbiology | journal | 0.431 Q3 | 57 | 26 | 79 | 669 | 93 | 78 | 1.08 | 25.73 |
73 | Iranian Journal of Microbiology | journal | 0.388 Q3 | 17 | 51 | 186 | 1770 | 235 | 181 | 1.02 | 34.71 |
74 | Enfermedades Infecciosas y Microbiologia Clinica | journal | 0.373 Q3 | 37 | 242 | 585 | 3291 | 373 | 391 | 0.92 | 13.60 |
75 | Microbial Risk Analysis | journal | 0.370 Q3 | 4 | 16 | 23 | 953 | 27 | 20 | 1.35 | 59.56 |
76 | British Journal of Biomedical Science | journal | 0.353 Q3 | 38 | 39 | 113 | 1302 | 160 | 104 | 1.83 | 33.38 |
77 | Revista Argentina de Microbiologia | journal | 0.351 Q3 | 21 | 88 | 218 | 1679 | 170 | 175 | 0.98 | 19.08 |
78 | Polish Journal of Microbiology | journal | 0.328 Q3 | 27 | 64 | 182 | 2081 | 190 | 181 | 0.81 | 32.52 |
79 | Le infezioni in medicina : rivista periodica di eziologia, epidemiologia, diagnostica, clinica e terapia delle patologie infettive | journal | 0.324 Q3 | 16 | 66 | 183 | 1629 | 139 | 171 | 0.88 | 24.68 |
80 | Infectious Disorders - Drug Targets | journal | 0.323 Q3 | 45 | 29 | 87 | 905 | 71 | 75 | 1.02 | 31.21 |
81 | Postepy Higieny i Medycyny Doswiadczalnej | journal | 0.301 Q3 | 23 | 86 | 465 | 463 | 367 | 465 | 0.75 | 5.38 |
82 | Mikrobiyoloji Bulteni | journal | 0.296 Q3 | 17 | 44 | 206 | 1004 | 118 | 199 | 0.55 | 22.82 |
83 | Indian Journal of Pathology and Microbiology | journal | 0.276 Q3 | 27 | 172 | 543 | 2411 | 279 | 390 | 0.59 | 14.02 |
84 | Revista Espanola de Quimioterapia | journal | 0.254 Q3 | 22 | 103 | 220 | 2244 | 118 | 197 | 0.53 | 21.79 |
85 | Clinical Microbiology Newsletter | journal | 0.248 Q3 | 17 | 35 | 110 | 935 | 61 | 103 | 0.54 | 26.71 |
86 | Asian Pacific Journal of Tropical Disease | journal | 0.230 Q3 | 23 | 164 | 795 | 5284 | 642 | 776 | 0.75 | 32.22 |
87 | Human Microbiome Journal | journal | 0.220 Q3 | 2 | 15 | 11 | 572 | 5 | 10 | 0.50 | 38.13 |
88 | GERMS | journal | 0.219 Q3 | 7 | 24 | 54 | 539 | 34 | 36 | 1.04 | 22.46 |
89 | Enfermedades Infecciosas y Microbiologia Clinica Monografias | journal | 0.215 Q3 | 4 | 0 | 42 | 0 | 10 | 19 | 0.64 | 0.00 |
90 | Epidemiologie, Mikrobiologie, Imunologie | journal | 0.208 Q3 | 11 | 33 | 126 | 1093 | 66 | 123 | 0.53 | 33.12 |
91 | African Journal of Clinical and Experimental Microbiology | journal | 0.192 Q3 | 2 | 3 | 14 | 88 | 4 | 14 | 0.17 | 29.33 |
92 | Medycyna Doswiadczalna i Mikrobiologia | journal | 0.190 Q3 | 9 | 0 | 57 | 0 | 23 | 57 | 0.44 | 0.00 |
93 | Chinese Journal of Endemiology | journal | 0.188 Q4 | 7 | 39 | 337 | 490 | 21 | 325 | 0.08 | 12.56 |
94 | Internet Journal of Microbiology | journal | 0.183 Q4 | 7 | 1 | 5 | 53 | 1 | 5 | 0.20 | 53.00 |
95 | Japanese Journal of Antibiotics | journal | 0.182 Q4 | 17 | 0 | 72 | 0 | 22 | 72 | 0.26 | 0.00 |
96 | Infectious Diseases in Clinical Practice | journal | 0.177 Q4 | 19 | 102 | 369 | 1988 | 81 | 321 | 0.28 | 19.49 |
97 | Clinical Epidemiology and Global Health | journal | 0.162 Q4 | 4 | 65 | 121 | 913 | 30 | 100 | 0.28 | 14.05 |
98 | Archives of Clinical Microbiology | journal | 0.158 Q4 | 5 | 0 | 22 | 0 | 10 | 21 | 0.62 | 0.00 |
99 | International Arabic Journal of Antimicrobial Agents | journal | 0.155 Q4 | 5 | 0 | 14 | 0 | 5 | 14 | 1.00 | 0.00 |
100 | Turk hijiyen ve deneysel biyoloji dergisi. Turkish bulletin of hygiene and experimental biology | journal | 0.152 Q4 | 2 | 65 | 112 | 1515 | 17 | 112 | 0.14 | 23.31 |
101 | Australian Journal of Medical Science | journal | 0.138 Q4 | 5 | 0 | 25 | 0 | 3 | 23 | 0.27 | 0.00 |
102 | Zentralsterilisation - Central Service | journal | 0.136 Q4 | 8 | 1 | 102 | 6 | 15 | 54 | 0.16 | 6.00 |
103 | Postepy Mikrobiologii | journal | 0.134 Q4 | 9 | 43 | 108 | 2818 | 31 | 107 | 0.34 | 65.53 |
104 | Roumanian Archives of Microbiology and Immunology | journal | 0.134 Q4 | 13 | 0 | 31 | 0 | 7 | 31 | 0.00 | 0.00 |
105 | Infectio | journal | 0.133 Q4 | 5 | 35 | 107 | 911 | 27 | 91 | 0.26 | 26.03 |
106 | Malaysian Journal of Microbiology | journal | 0.131 Q4 | 11 | 30 | 151 | 952 | 32 | 150 | 0.18 | 31.73 |
107 | Zhurnal Mikrobiologii Epidemiologii i Immunobiologii | journal | 0.130 Q4 | 11 | 0 | 265 | 0 | 53 | 265 | 0.21 | 0.00 |
108 | Klinicka Mikrobiologie a Infekcni Lekarstvi | journal | 0.129 Q4 | 9 | 16 | 66 | 263 | 20 | 52 | 0.29 | 16.44 |
109 | Reviews in Medical Microbiology | journal | 0.127 Q4 | 24 | 29 | 85 | 1256 | 26 | 80 | 0.37 | 43.31 |
110 | Antibiotiki i Khimioterapiya | journal | 0.124 Q4 | 9 | 26 | 138 | 581 | 29 | 138 | 0.24 | 22.35 |
111 | Kasmera | journal | 0.123 Q4 | 5 | 14 | 42 | 334 | 2 | 37 | 0.04 | 23.86 |
112 | Klimik Dergisi | journal | 0.116 Q4 | 6 | 41 | 99 | 1005 | 18 | 83 | 0.24 | 24.51 |
113 | Problems of Infectious and Parasitic Diseases | journal | 0.114 Q4 | 5 | 0 | 54 | 0 | 3 | 53 | 0.00 | 0.00 |
114 | Enfermedades Infecciosas y Microbiologia | journal | 0.112 Q4 | 6 | 18 | 26 | 357 | 3 | 22 | 0.00 | 19.83 |
115 | Acta Microscopica | journal | 0.111 Q4 | 5 | 0 | 67 | 0 | 11 | 67 | 0.20 | 0.00 |
116 | Chinese Journal of Infection and Chemotherapy | journal | 0.109 Q4 | 7 | 134 | 333 | 1574 | 19 | 315 | 0.07 | 11.75 |
117 | Internet Journal of Infectious Diseases | journal | 0.108 Q4 | 5 | 0 | 3 | 0 | 0 | 3 | 0.00 | 0.00 |
118 | IEEE International Conference on Nano/Molecular Medicine and Engineering, NANOMED | conference and proceedings | 0.106 | 3 | 21 | 22 | 339 | 3 | 20 | 0.15 | 16.14 |
119 | Acta Microbiologica Hellenica | journal | 0.106 Q4 | 2 | 19 | 51 | 627 | 1 | 51 | 0.00 | 33.00 |
120 | Mikologia Lekarska | journal | 0.104 Q4 | 12 | 0 | 6 | 0 | 0 | 6 | 0.00 | 0.00 |
121 | Giornale Italiano di Medicina Tropicale | journal | 0.102 Q4 | 6 | 0 | 12 | 0 | 0 | 12 | 0.00 | 0.00 |
122 | Krankenhaushygiene und Infektionsverhutung | journal | 0.100 Q4 | 4 | 17 | 72 | 62 | 0 | 49 | 0.00 | 3.65 |
123 | Infektoloski Glasnik | journal | 0.100 Q4 | 6 | 0 | 61 | 0 | 1 | 52 | 0.00 | 0.00 |
موسسه انتشاراتی اشراق با بیش از 5 سال سابقه در زمینه چاپ مقالات در نشریات معتبر با ضریب تاثیر مثبت همواره با ارائه خدمات حرفهای و تخصصی و مشاورههای تخصصی رایگان در خدمت پژوهشگران بزرگوار است.
موسسه اشراق حاصل تلاش پژوهشگران و محققین برای چاپ مقالات ارزشمند خود در مجلات مورد تایید وزارت علوم را هموار میسازد و خدمات ترجمه، فرمتبندی و مشاوره را ارائه میدهند تا پژوهشگران بتوانند مقالات خود را در مجلات مورد تایید وزارت علوم چاپ کنند.
راههای ارتباطی با موسسه انتشاراتی اشراق
کارشناسان و مشاوران موسسه انتشاراتی اشراق به صورت تماموقت حتی در روزهای تعطیل آماده ارائه خدمات حرفهای و باکیفیت به مشتریان و کاربران خود هستند. برای دریافت مشاوره میتوانید از طریق سایت به صورت آنلاین با مشاورین موسسه گفتوگو کنید و یا از طریق تماس تلفنی با شمارههای زیر در ارتباط باشید:
eshragh_company
isi.eshragh@gmail.com
09149724933
041-33373424
خیر، بسته به سطح مقاله، مجلات Scopus، PubMed، ISC و علمی-پژوهشی داخلی نیز پیشنهاد میشوند.
بله، حتی خدمات ترجمه، ویراستاری و فرمتبندی نیز ارائه میشود.
خیر، مجلات معتبر بین المللی نیز جهت چاپ مقالات انگلیسی معرفی میشوند.